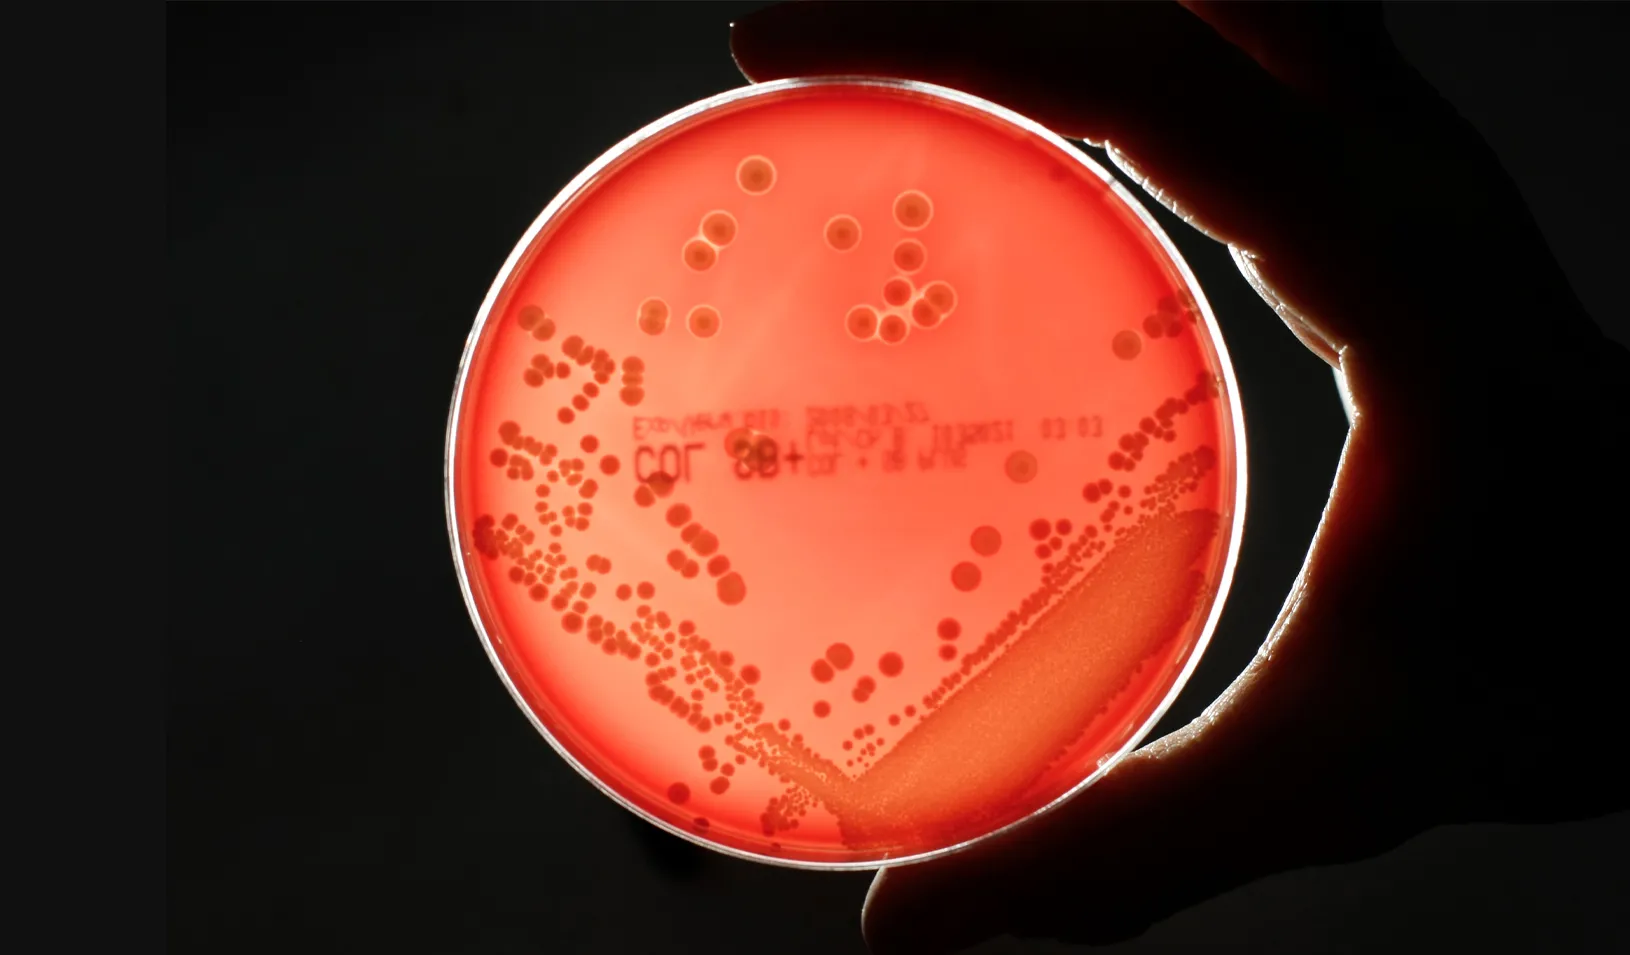
MRSA (Methicillin-resistant Staphylococcus aureus) bacteria strain is seen in a petri dish containing agar jelly for bacterial culture in a microbiological laboratory. MRSA is a drug-resistant "superbug", which can cause deadly infections. | Credit: REUTERS/Fabrizio Bensch.

February 23, 2022
| by Donna AlvaradoIn 2019, more than 2.8 million people in the U.S. got sick from illnesses caused by antibiotic-resistant bacteria. More than 35,000 of them died.
Yet pharmaceutical companies aren’t rushing to find new treatments for these constantly evolving threats. That’s in part because the potential to earn a reasonable profit from the development of antibiotics has withered. Even when companies are willing to take a gamble on finding a drug that works, they face an unpredictable market as well as pressure to limit usage and keep prices low.
“These factors have combined to destroy returns,” says Kevin A. Schulman, a professor of operations, information and technology (by courtesy) at Stanford GSB and a professor of medicine at Stanford.
Working with Neil Gandhi, an ER doctor who graduated from Stanford with MBA and MD degrees in 2021, Schulman has proposed a way to help thwart antibiotic resistance by accelerating the production of new drugs. They propose a public-private partnership to create predictable financial returns for companies that develop game-changing antibiotics. The partnership could deliver additional public funding, generated by add-on payments under Medicare that would provide $100 million over time for a company that produces a drug proven to work.
“We’re interested in creating a financial incentive for innovators,” says Schulman. New antibiotics are necessary, he says, “because our current ones aren’t always going to be effective. Increasingly, they aren’t.”
Gandhi, currently a resident in emergency medicine at UCLA, says he often sees patients with bacterial illnesses. “I absolutely want to dive deep into this problem,” he says, to “create a solution that can have impact.”
The War on Bugs
The Centers for Disease Control (CDC) warns that antibiotic resistance is one of “the greatest global public health challenges of our time.” The agency has identified 18 bacteria and fungi that threaten public health because they have evolved into forms that shrug off antibiotics. Among those defined as serious threats are MRSA (methicillin-resistant Staphylococcus aureus), a resistant form of the bacteria behind common staph infections; and Campylobacter, which is spread by contaminated food, especially undercooked chicken and eggs.
However, the pipeline for new antibiotics has slowed to a trickle. A recent report found that 43 antibiotics were in development in late 2020, yet only a small fraction of those will make it to market. One of the last venture capitalists in Silicon Valley to invest in antibiotic development told Schulman they have pulled out of this market due to the challenging economics. Schulman thinks the way to turn that around is to offer a predictable path to returns “that will make it attractive again.”
Schulman cites the federal Operation Warp Speed that helped produce the innovative mRNA COVID vaccines as a dramatic example of what can be done to spur new drug development. The government made a commitment to pharmaceutical companies that “if you develop these vaccines, we’ll buy them,” he explains. That kind of deal is unlikely to be repeated, short of another global pandemic, but the success of this private-public partnership could be a model.
Schulman and Gandhi don’t propose to pay companies upfront before knowing if their candidate antibiotics are effective (unlike the Warp Speed program). Instead, they are suggesting a private-public partnership with more checks and balances. In a paper published in December in the journal Health Affairs, they describe a way to use Medicare payments to attract companies into the field.
Their plan would guarantee reliable and stable payments for new antibiotics only after they are shown to be effective. “If you are able to get a product through the hurdles set by the FDA and get to market, here’s the payment structure that you’ll get,” Schulman says. That way, “we don’t have the risk of picking winners.”
Investing in Innovation
The goal, Schulman says, is not to produce a new cost-reimbursement plan but to create incentives for innovation. The paper outlines three models that might accomplish this. Each would stack add-on payments onto the basic price that Medicare and other customers would pay for a new antibiotic. Using any of these financially equivalent models, the additional payments would create a $100 million return for a company that produces an effective drug.
Two of the models would fund the incentives through add-ons to existing Medicare payments. Medicare is a logical vehicle for this approach since it pays for much of the care for patients with drug-resistant illnesses, many of whom are over 65. (The new drugs would still be available to non-Medicare patients through private insurance.) Using these models, Schulman and Gandhi calculate that a drug company might receive between $637 and $3,187 for each treatment course of a new MRSA drug.
The other model would apply an add-on to the bills of all patients who receive care for a resistant infection, including those with private insurance. This approach would require the lowest add-on payments — an estimated $310 per course of an anti-MRSA treatment. Schulman and Gandhi also analyzed the economics of developing a $100 million to $300 million R&D subsidy program that would reduce the add-on payments required from Medicare.
A similar incentive program already offers add-ons to Medicare payments for companies that develop innovative medical treatments, but the model described in the paper would make some fundamental changes to the program. “The payment rates we talk about are much greater,” Schulman says. “At the same time, our model is actually conservative in terms of returns.”
“If the model does not spur the investments we hope to see, the payment rates can be increased in an iterative fashion,” he says. “With this approach, we hope we can strike a balance that provides incentives for a stable market but be accountable to the public as well.”
Gandhi says these financial incentives could lure venture capital back to funding the startups ready to invent new antibiotics. “We have the talent and the resources to fight infectious diseases,” he says. “But we need government support in order to create solutions.”
For media inquiries, visit the Newsroom.